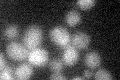
YNL054W
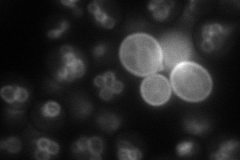
YNL054W
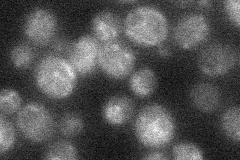
YNL054W
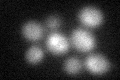
YNL054W

View description
Integral vacuolar membrane protein involved in vacuole inheritance and morphology; activates Fab1p kinase activity under basal conditions and also after hyperosmotic shock
Localization:
Intensity:
Fold change:
Significance:
-
C’ GFP library in SD
below threshold14.82 -
N' NOP1pr-GFP in SD
vacuole membrane52.9029 -
N' TEF2pr-mCherry in SD

punctate,vacuole membrane57.2967 -
N' NATIVEpr-GFP in SD
vacuole membrane21.8441 -
N' TEF2pr-VC and Cyto-VN in SD

punctate47.3614 -
C’ GFP library in SD+DTT
cytosol17.691.19No -
C’ GFP library in SD+H2O2

cytosol16.891.13No -
C’ GFP library in Starvation Media

cytosol19.341.3No -
C’ GFP library on the background of Pup2-DaMP

below threshold -
C’ GFP library on the background of CCT mutant

below threshold14.30860.964952No
